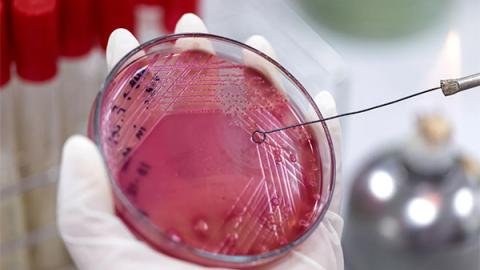
dailymaveric

Pneumococcal Colonization Dynamics and Antimicrobial Resistance Using Shotgun Metagenomic Sequencing in South African Infants
A maximum likelihood whole genome phylogenetic tree of pneumococcal isolates.
Read more

Pseudomonas aeruginosa
A citywide, community-based, clonal outbreak of Pseudomonas aeruginosa, during the recent drought in Cape Town.

Carbapenem-resistant Serratia marcescens
The genomic characterization of carbapenem-resistant Serratia marcescens at Groote Schuur Hospital in South Africa, indicating the emergence and spread of resistance and virulence in this organism.
How vaccines could help combat drug resistance and transform SA’s public health outcomes
By preventing infections, vaccines limit the emergence and transmission of susceptible and drug-resistant strains, lower the risk of secondary infections and reduce the need for antimicrobial drug use.
Read more

Newsletter 2024 - 2025
Let’s take a moment to reflect on all the incredible events and activities we had lined up last year! From empowering women
with power walks to stalls of fermented flavors and everything in between, it was truly a memorable celebration.
Read more

One Health Unit
The Division of Microbiology launched the One Heath Unit on the 25 March 2025 with a think tank: Towards next sequencing (including metgenomics) across a ONE HEALTH spectrum across South Africa and the UK.
Read more






